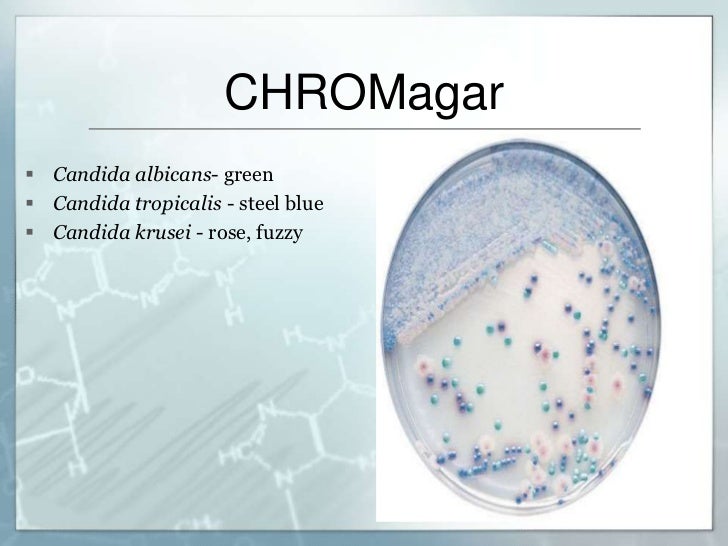

What is the role of presumptive therapy in the treatment of tuberculosus?
Presumptive treatment was defined as treatment administered at time of testing; all others were classified as standard care. Patients were classified as receiving test results if they called the clinic or returned for treatment after testing. To estimate the association between treatment type and receipt of results, we
What is presumptive eligibility?
Presumptive Diagnosis and Treatment of Common STIs OCTOBER 28 TH 2020 Presented by the NYC STD Prevention Training Center (PTC) at Columbia University and the Michigan Department of Health and Human Services. The webinar will begin shortly.
What is a “presumptive” service connection?
Presumptive therapy is of benefit in that it stops progression of the disease at an early stage and decreases the potential for spread of tuberculous infection. In addition, such therapy coupled with systematic reevaluation of patients substantiates the diagnosis or indicates that further evaluation is needed.
What is a presumptive positive covid-19 test result?
Feb 06, 2019 · presumptive treatment after they arrive in the United States. • All Middle Eastern, Asian, North African, Latin American, and Caribbean refugees, with exceptions noted in this document, should receive presumptive therapy with: o Albendazole, single dose of 400 mg (200 mg for children 12-23 months)
Objectives
Presumptive antibiotic treatment may be given for Chlamydia trachomatis (CT) and Neisseria gonorrhoeae (GC) infections before a laboratory diagnosis is established, but overtreatment can increase resistance rates.
Methods
We performed a retrospective cohort study of all patients tested for CT/GC in an urban academic ED during a 6-month period in 2015. Presumptive treatment prevalence, overtreatment and undertreatment proportions, and CT- and GC-positive test proportions were calculated with 95% Wald confidence interval (CI) and compared across age and sex.
Results
Of 209 included cases (male n = 3, female n = 206), 27 (13%; CI, 8%–18%) received presumptive treatment for CT and 19 (9%; CI, 5%–14%) for GC. Seven cases (3%; CI, 1%–6%) were positive for CT and 0 for GC.
Conclusions
Given the low CT/GC incidence and good follow-up, at our institution, it would be reasonable to wait for a laboratory diagnosis rather than give presumptive treatment.
